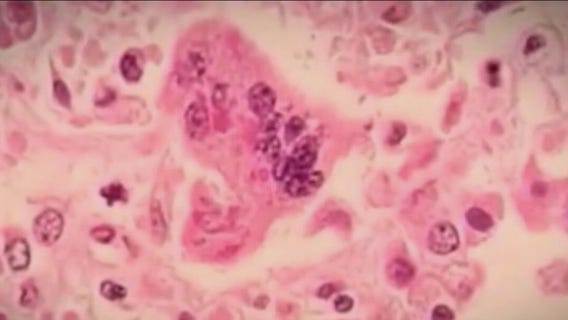
7 measles cases reported at Pilsen migrant shelter

Migrant families exposed to measles at Pilsen shelter quarantining in Chicago hotel
Several migrant families who have been exposed to measles at the Pilsen shelter are quarantining at a Chicago hotel to help mitigate the spread.
CDC dispatches team to Chicago as measles cases prompt concerns
As measles cases tick upward, the Chicago Department of Public Health, on Tuesday, confirmed three more cases of the disease at the city’s migrant shelter in Pilsen.
Activists in Pilsen push for property tax relief using TIF funds
Facing a record-high property tax hike, activists in Pilsen have launched a campaign advocating for the utilization of TIF money to assist in paying their tax bills.
Measles cases in Chicago rise to five, prompting CDC assistance and quarantine measures
Officials revealed on Monday that the number of confirmed measles cases in Chicago since last week is now up to five – most of them, among new arrivals.
Man arrested after allegedly robbing woman in Pilsen: police
A man was arrested in connection to a robbery in Chicago's Pilsen neighborhood on Sunday.
Pilsen bakery targeted by graffiti sends message of resilience
It's a bitter taste for a Chicago business that makes sweet confections, after someone graffitied an unwelcome message on a new bakery in Pilsen.